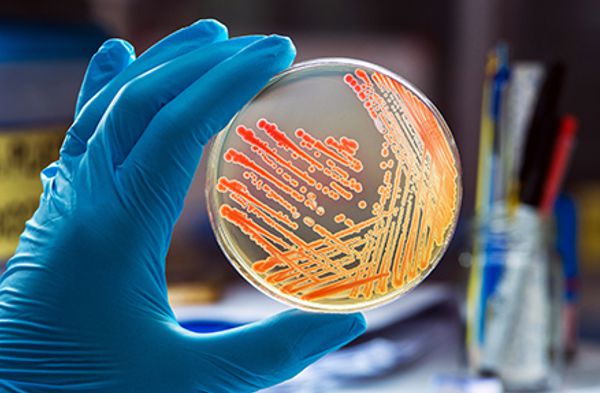
service

Welcome to Doctor Laboratory (pvt) Ltd Kurunegala
Welcome you to Doctor Lab Official website. We offer more than 150+ laboratory tests using modernized high-tech fully automated analyzers. And also our staff is highly skilled & knowledgeable. All processes are taking place under the supervision of an expert panel of consultants in relevant disciplines. Our team of physicians is made up of some of the best in the field, including consultant pathologists, microbiologists, biochemists, haematologists and general practitioners who work together to provide you with a clear picture of your current health.
We are committed to provide you with highly accurate, timely delivered, customer friendly and reliable laboratory service. We consider it as our responsibility to give you a result which will guide your healthcare provider to effectively manage your condition.
Why Choose Doctor Lab?

-
Excellent Quality Standards
-
No hidden charges & Affordable price
-
Check Reports via Online & SMS
-
Quality Assurance
-
Modern Technology with Quality Analyzers
-
On-time Delivery of Results
-
Comprehensive testing

Well Experienced & Customer Friendly Staff

High Quality Analyzers